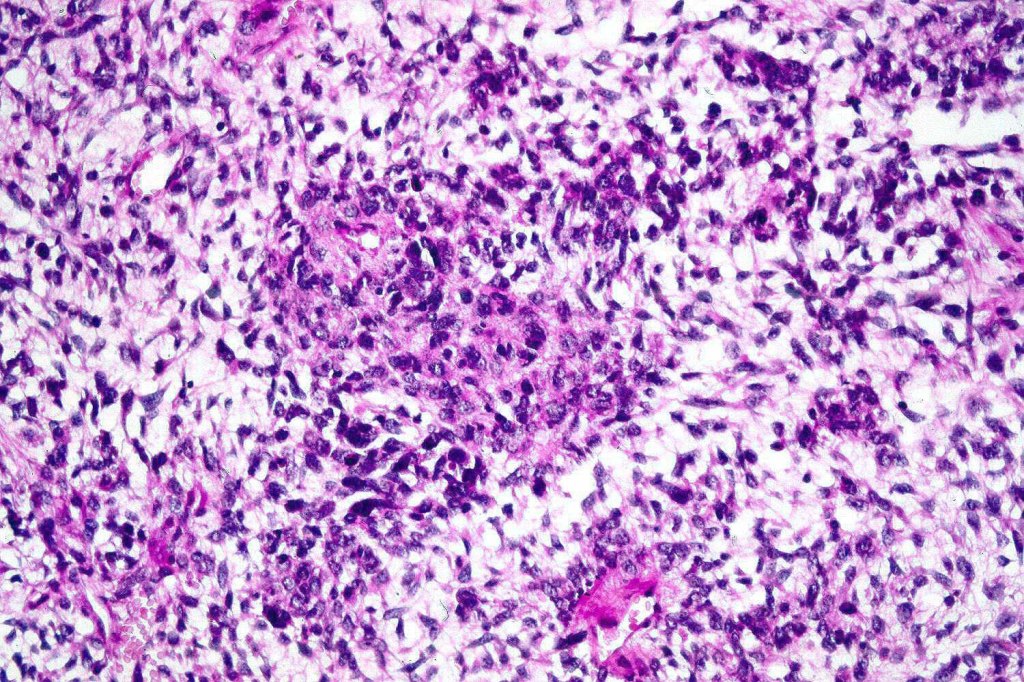

A rare variant of melanoma in which stromal cells produce excess acid mucopolysaccharides inprting a striking myxoid quality. The mucin is Alcian blue & colloidal iron positive, DPAS negative and the melanoma cells stain with typical markeres including S100 & HMB45. It may be seen in primary, recurrent or most often in metastatic lesions. The tumor cells are typically small although occcasionally they are epithelioid. Melanin is often sparse or even avsent making diagnosis difficult. In some examples, a pseudoglandular appearance is seen.

The differential diagnosis is very wide and can include numerous myxoid soft tissue tumors and epthelial mucin-secreting carcinomas. Diagnosis depends on clinical history, mucin stains and the judicious use of immunohistochemistry.
Leave a comment